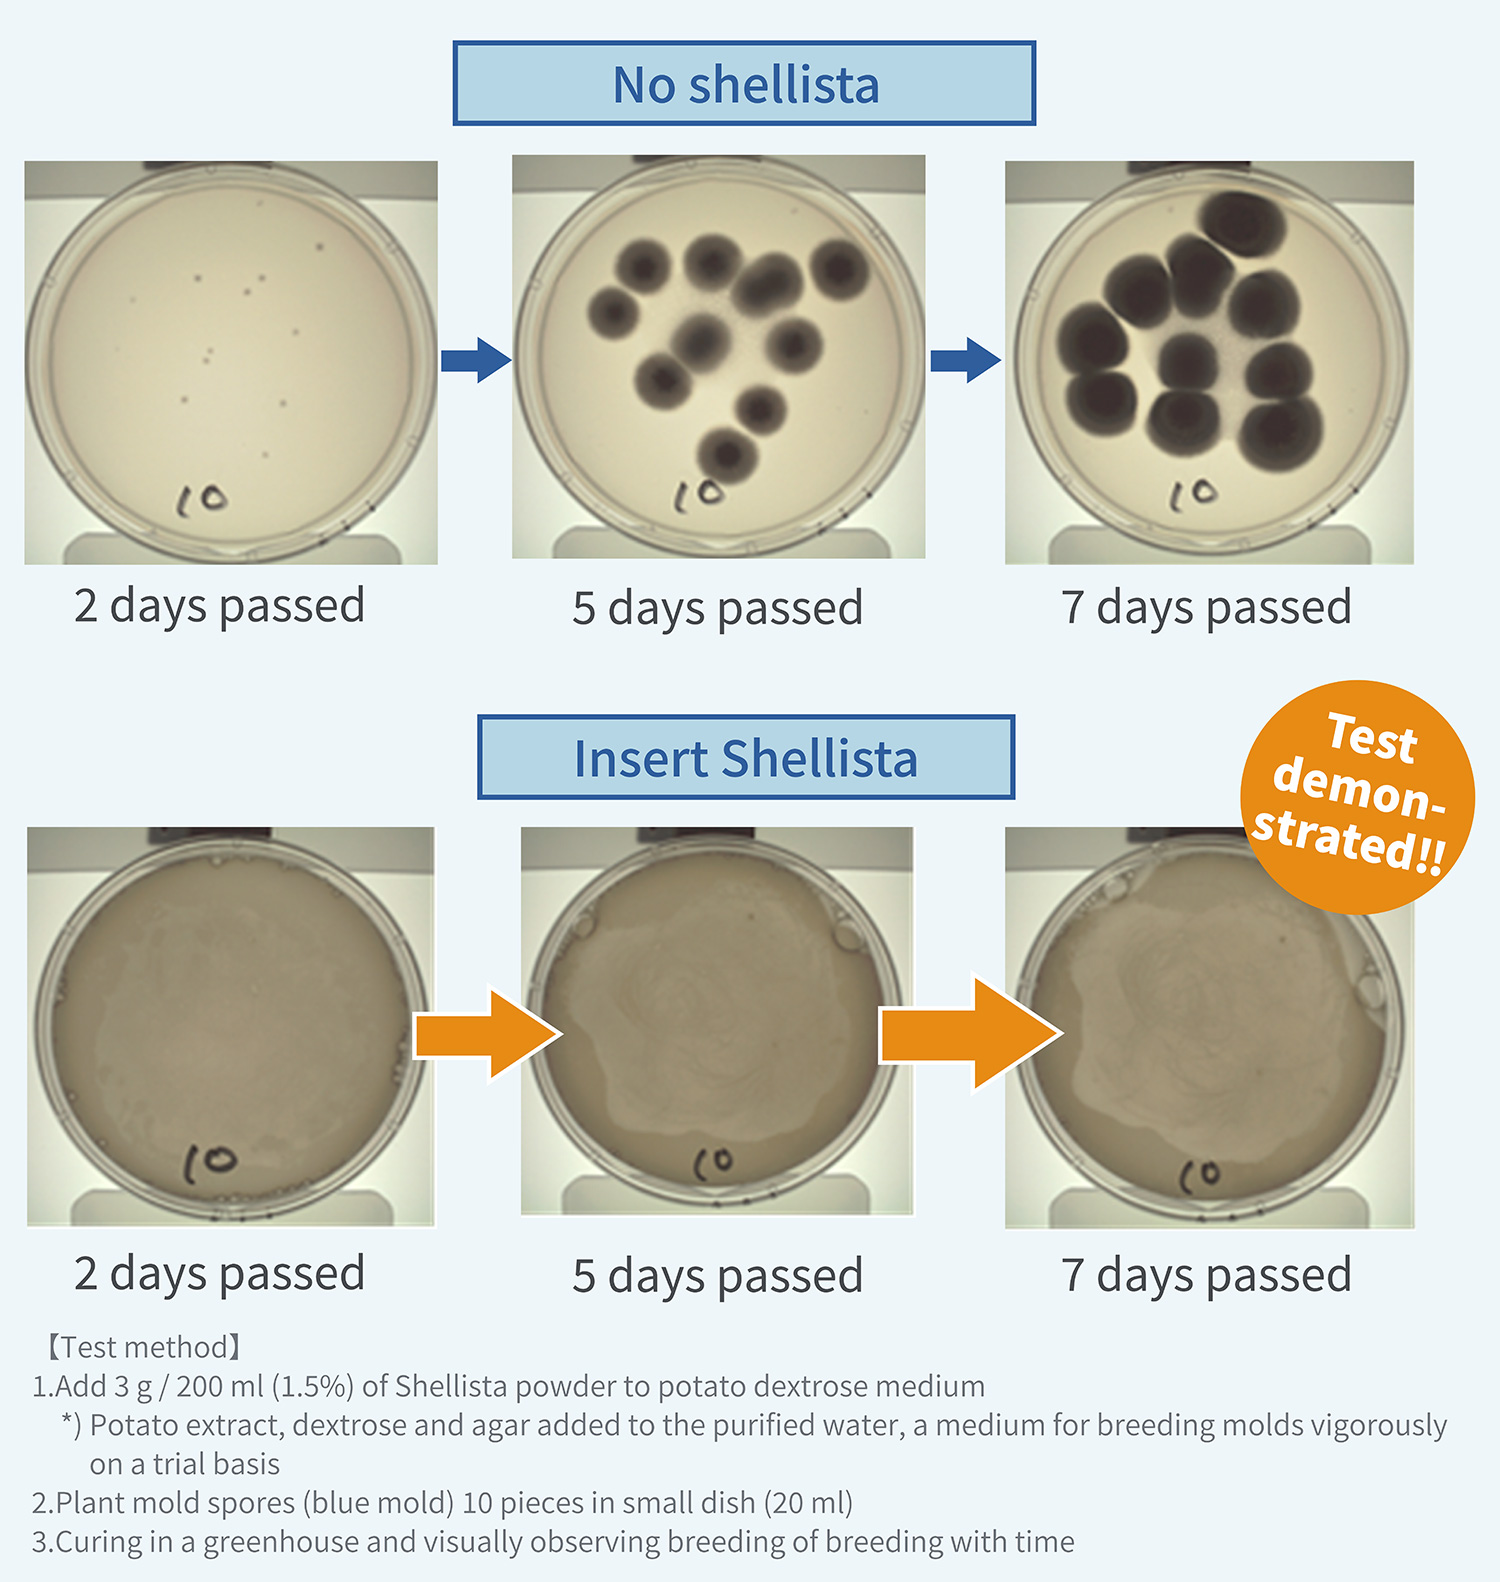
Anti-mold test result example

Shellista sanitisation deodorant powder

The structure that the sanitisation washing effect and the freshness last longer

It would be turn into the strong alkaline when it dissolve Shellista powder in the water and the dirts or the pesticide residue, the wax which attached to the surface will peeled off by soaking the fruits and the vegetables. Furthermore, various germs and the virus are sanitize as well as the anti-mold effect will be continue for a long time, and the effect to maintain the freshness of the fruits and the vegetables last longer. Moreover, this effect made it happen with 100% of the natural ingredients. Shellista is the ideal product for a person who is keeping the healthy eating habits in mind.
Surprising washing effect that the pesticide residue and the wax float

You can see the dirts floating after 10 minutes by soaking the vegetables and the fruits with Shellista powder. This is the pesticide residue or the wax which attached on the surface of the vegetables and the fruits. There is the possibility to eat it without remove it by washing in the water and may become the health problem. Why Shellista can remove the pesticide residue and the wax like this? Because it is the strong alkaline action of Shellista. It is a great point of Shellista that it can remove the pesticide residue only by the power of nature without using the synthetic surfactant entirely.
Strong sanitisation ability
Shellista strong alkaline power sanitize various bacteria and viruses. When looking at the eradication test, bacteria decreased by 99.9% in 10 minutes and non-enveloped virus by 78.5% (below the detection limit).

Baby feeding bottle and tooth compaction, child disinfection etc. as a mug.
With Shellista powder, you can sterilize your baby bottle, tooth compaction, mugs etc in a batch. It is very easy to use because it is 100% natural ingredient and there is no irritating odor, unlike chlorine type goods like a typical disinfectant. Please also use a wide range as small toy toys and so on are sterilized cleanly. Also, if you soaked in shelista and wash it carefully and disinfected, Since there is also an anti-mildew effect even after that, it can be used as a mildew-proofing agent even in the rainy season etc.

High anti-mold effect
A place to be worried about the mold occurring to the room and the food in Japan when it is the high temperature and the humidity. Of course it occurs in the summer time and the rainy season, but the mold may becomes in condition to be easy to occur under the influence of heating and a humidifier even in the winter. The sanitisation deodorant powder of Shellista plays an active part in the mold measures.
Freshness lasts longer
As for the vegetables by using Shellista, the sanitisation effect lasts longer in comparison with the general sanitisation deodorant cleaner included the sodium hypochlorite and a case only for washing in the water. In other words, it means that the freshness of the vegetables and the fruits lasts longer. We recommend to wash and soak the vegetables and the fruits with Shellista before putting them into the refrigerator as it will maintain the freshness for a long time.

Highly recommended usage
Baby bottle

Because the mouthpieces of the baby bottle which milk and saliva attach to are the environment where the various germs are easy to propagate very much, it is necessary to sanitize it when you use it every time. It is a thing to use for a newborn baby, you want to choose the thing which you can convincing.
Baby food

Generally, baby food begins from 5 months for about 1 year after birth. Most of the mothers wants to make a baby food with relief and the safe ingredients. It is important to use the organic vegetables which the source is clear, but it is important to sanitize the bacteria and the virus.
Smoothie

There are many people drinking the smoothie and the cold press juice for the purpose of health and beauty. You can have more satisfaction if you use the fruits and the vegetables which are made careful about the pesticide residue.
Salad

When you eat the fruits and the vegetables raw, it is good to be careful about the pesticide residue and the wax in particular, and also the bacteria or the viruses. It is a good point that Shellista is made from 100% natural ingredients and the high sanitisation effect.
Bath

It would be drop the dirt of the bathtub by soaking Shellista in the hot water which collected in the bathtub and prevent breeding of the mold before you clean the bathtub everyday.
Washing machine

Laundry, sanitisation and deodorization of the washing machine are possible all at once. It would prevent an unpleasant smell to be caused to the room drying of the laundry and half-dried. Moreover, it would prevent the mold of the washing tub and prevent being yellowed, and remove slime and the bad smell of the outlet port. In addition, you can expect a stronger sanitisation effect because alkalinity is higher than sodium bicarbonate.
FAQs
-
Q Can you remove all the pesticides and the various germs?
-
A We do not conduct eradication tests etc. on all pesticides and bacteria / virus, but results that almost no bacteria and viruses are detected have come out.
-
Q Is the nutrition of vegetables and the fruits falls with the pesticide and the bacteria as well?
-
A No, it does not fall the nutrients if you soak it the recommended time (5-10 minutes).
-
Q Is it only on the surface of ingredients can remove the dirts and the bacterias?
-
A Yes, I am effective for the dirts and the various germs which attached to the surface.
-
Q Why is the water color changed after soaking the vegetables?
-
A A change of color may be caused depending on the kind of ingredients, but the quality does not have any problem. (e.g. The tomatoes with paddy and the burdocks with skin turn into green)
In addition, it may change the color when there are the dirt and the scratch on the surface of ingredients. -
Q The liquid became yellow when I soaked the rice. What is this?
-
A The reason why the liquid became yellow, oxidized oil of rice has begun to melt. The texture and the color of rice are spoiled when the soaking time is too long, please soak for [around 5 seconds].
-
Q Is there the point when I keep the vegetables after soaking them?
-
A An antibacterial effect increases by coating of calcium more when you keep it in the refrigerator after soaking ingredients without washing them away under running the water. There will be the white powdery thing that on the surface may attach when it dry, but there is not a problem even if you put it in a mouth because this is calcium. Please use it after wash if you are worry about.

sanitisation deodorant powder
100% of natural material of the sanitizer which processed the scallop shell of Ohotsuku, Hokkaido marine products by the original manufacturing method.
Ingredient: Shellfired calcium
Internal capacity: 100g
Country of origin: Japan
Price: 1,500yen (tax-included)
Usage
[sanitisation washing of the vegetables and the fruits]
Sprinkle approximately 5 times of this product on 1 liter of the water (approximately 1 g) and stir it well. Please soak the vegetables and the fruits for 5 – 10 minutes and wash them under the running water. Please shed the solution to a sink and close the cover of this product properly after use.
[Washing of the rice]
Put the water once again after you wash the rice, then sprinkle 1-2 times of this product and sharpen the rice for approximately five seconds and throws away the water and cook the rice as usual.
[sanitisation of the kitchenware and the dishes]
Sprinkle approximately 5 times of this product on 1 liter of the water (approximately 1 g) and stir it well and I soak the kitchenware and the dishes for 5-10 minutes and wash well. Please shed the solution to a sink and close the cover of this product properly after use.
[sanitisation washing of the washing machine]
Sprinkle approximately 5-10 times of this products on 20 liters of the water (approximately 1-2 g).
[sanitisation washing of the bathtub]
Sprinkle approximately 5-10 times (approximately 1-2 g) of this product on 20 liters of the water, then outrun the water in the bathtub in 5-10 minutes later and rinse it out enough.
Usage notes
- Please do not use it apart from the application.
- Please do not mix it with other sanitisation agents and the cleaners.
- Please make sure to close a cover properly as this product hates the moisture and please use it as early as possible after opening.
- When it attach to your eyes and mucous membrane by mistake, please wash it away with the water and please receive the diagnosis of the doctor.
- When you drink it by mistake, please gargle immediately and drink 2-3 cups of the water and please go and see a doctor.
- Please keep it out of reach of the infants.
- It may change the color by ingredients, but there is not the problem in the quality.
- This product is alkaline.
- We may change the design, the specifications without a notice for the quality improvement and the improvement of the product. Thank you for your understanding beforehand.
